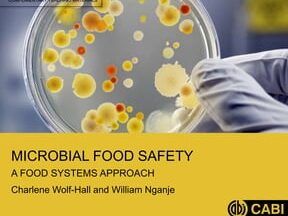

Your Guide to HealthEngine Medical Certificates: Benefits & Process
Are you in need of a medical certificate for work or personal reasons? Look no further than HealthEngine, a convenient […]
Your Guide to HealthEngine Medical Certificates: Benefits & Process Read More »